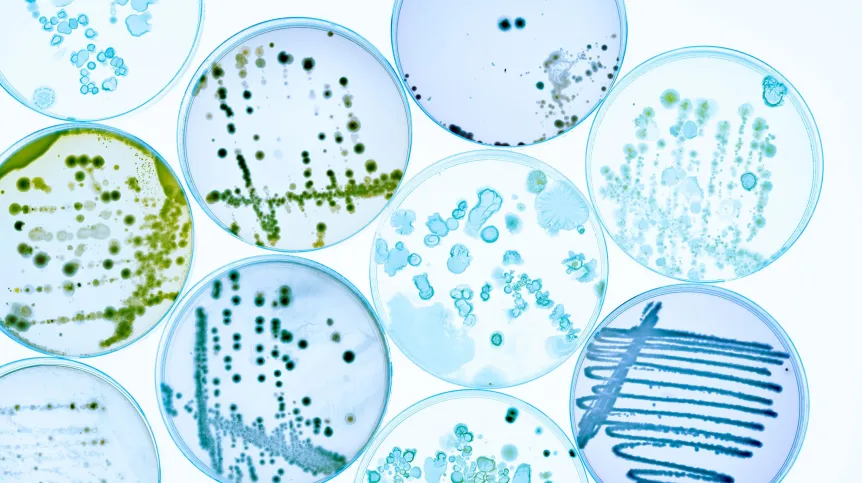
Fot. Adobe Stock

Po analizie dostępnej wiedzy, naukowcy z Chin nawołują, aby szeroko zająć się wpływem mikroskopijnych grzybów na rozwój i przebieg różnych rodzajów raka. Coraz więcej dowodów wskazuje, że również one mają istotny wpływ na powstawanie nowotworów, ich rozwój oraz odpowiedź na leczenie.
Autorzy opracowania, które ukazało się w piśmie „Research” – naukowcy z Shanghai Jiao Tong University School of Medicine - na podstawie dostępnej wiedzy podnoszą m.in. potrzebę uwzględnienia mykobiomu (obecnych w organizmie grzybów) w badaniach onkologicznych, związek między grzybami i bakteriami w przebiegu nowotworów czy wykorzystanie tej wiedzy w terapiach.
Badacze podkreślają, że pomimo niewielkiej liczebności w tkankach nowotworowych (około 4–13,3 proc.), grzyby wykazują szeroką obecność, wysoką aktywność sygnałową oraz specyficzność typów w wielu nowotworach, w tym płuc, piersi, jelita grubego i trzustki.
Dzięki wysoce czułym technikom, takim jak sekwencjonowanie genów, zidentyfikowano już grzyby związane z nowotworami, w tym Candida, Malassezia i Aspergillus. Grzyby te mogą sprzyjać rozwojowi guza poprzez aktywację szlaków immunosupresyjnych lub wydzielanie czynników rakotwórczych – tłumaczą specjaliści.
Jednocześnie okazuje się, że grzyby i bakterie wykazują synergistyczne lub antagonistyczne interakcje, wpływając na mikrośrodowisko immunologiczne i odpowiedź na terapię.
Modulowanie mykobiomu (np. za pomocą leków przeciwgrzybiczych) może wzmacniać odporność przeciwnowotworową – twierdzą naukowcy.
Wstępne potwierdzenie tego potencjału terapeutycznego pojawiło się już w niektórych badaniach przedklinicznych i klinicznych.
W przyszłości – zdaniem ekspertów - badania nad grzybami w onkologii będą przesuwać się od sprawdzania korelacji w stronę analizy przyczynowości. Nowoczesne techniki biologiczne i informatyczne mają pozwolić na stworzenie bazy danych ekosystemu grzybów nowotworowych.
W praktyce klinicznej mają natomiast być stosowane biomarkery łączące grzyby i bakterie do wczesnego przesiewu, prognozowania przebiegu choroby oraz przewidywania odpowiedzi na immunoterapię.
Ponadto leki przeciwgrzybicze prawdopodobnie znajdą nowe zastosowania onkologiczne, a równolegle będą powstawać nowe terapie.
Specjaliści z Chin mówią także o przeszczepach grzybów kałowych, osłabionych grzybów modyfikowanych inżynieryjnie oraz o spersonalizowanych „grzybowych receptach”.
Zdaniem naukowców potrzebne jest szersze uznanie roli grzybów w chorobach onkologicznych.
Równocześnie inwestycje publiczne powinny, według badaczy wspierać rozwój ram etycznych, systemów nadzoru nad opornością na środki przeciwdrobnoustrojowe oraz protokołów oceny toksyczności.
„Ostatecznie umożliwi to stworzenie precyzyjnych metod diagnostycznych i terapeutycznych opartych na mykobiomie, przynoszących korzyści pacjentom onkologicznym” – podsumowuje chiński zespół.
Marek Matacz (PAP)
mat/ agt/
Fundacja PAP zezwala na bezpłatny przedruk artykułów z Serwisu Nauka w Polsce pod warunkiem mailowego poinformowania nas raz w miesiącu o fakcie korzystania z serwisu oraz podania źródła artykułu. W portalach i serwisach internetowych prosimy o zamieszczenie podlinkowanego adresu: Źródło: naukawpolsce.pl, a w czasopismach adnotacji: Źródło: Serwis Nauka w Polsce - naukawpolsce.pl. Powyższe zezwolenie nie dotyczy: informacji z kategorii "Świat" oraz wszelkich fotografii i materiałów wideo.













